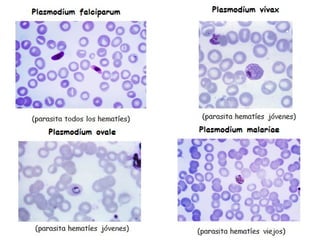

Más contenido relacionado
PPT
PPTX
Evolución de instrumentos de la medicina DOCX
PPTX
PDF
PPTX
DOCX
PPT
Projecto curricular de turma uma perspectiva ... Destacado
PDF
Lista de Graduação Definitiva – Terapeuta da Fala – Horário nº 3 DOCX
Spectacle american culture DOCX
DOCX
Tarea 4 Promoción al Consumidor PDF
DOCX
PPT
PDF
Mindsquare expertisegebieden PDF
Aviso nº 8 - contrataçao de escola DOCX
PDF
RPI_Univ_003_Final_MS_Degree DOCX
PDF
PDF
PDF
DOCX
Más de José Ramón Olalla Celma
PPTX
CANVAS para el Diseño del Entorno de Aprendizaje PPTX
INTELIGENCIAS MÚLTIPLES Y TAC PPTX
Realidad aumentada en el aula PPTX
APRENDIZAJE BASADO EN PROYECTOS PPTX
PPT
PPTX
INTELIGENCIAS MÚLTIPLES Y TAC PPTX
Vídeo educativo, vídeo enriquecido PPTX
PPTX
PPT
UNA METODOLOGÍA DE LAS TIC Y CON LAS TIC PPTX
PPTX
PPS
PPTX
PDF
Escultura renacentista en España PDF
Arquitectura renacentista en España PDF
Pintura renacentista en España PDF
PDF